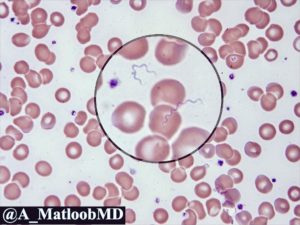
image

Общие сведения о возвратных тифах
Возвратный эпидемический тиф (он же европейский тиф или вшивый, возвратная лихорадка, спирохетоз возвратный) – трансмиссивная острая антропонозная болезнь, возбудителями которой являются определенные спирохеты (боррелии). Это заболевание характеризуется чередованием эпизодов повышения температуры и ее нормализации, а также общей интоксикацией.
У Анны Гордеевой была та же проблема — муж пил, бил, тащил все из дома…
Но Аня нашла решение! Её муж перестал уходить в запои и в семье у них все наладилось.
Читайте, с помощью чего ей это удалось — статья
История и географическое распространение
Клиническая картина впервые была описана еще известнейшим врачом древности Гиппократом. Однако, многие столетия все тифы (в том числе и возвратный) рассматривали как одно заболевание, то есть не было деления на брюшной, возвратный, сыпной тиф.
Клещевой возвратный тиф был определен как отдельное заболевание только в конце 19 века, когда прозектор Берлинского госпиталя Карл Обермейер впервые выделил его возбудитель, который впоследствии получил соответствующее название – спирохета Обермейера.
Наиболее высокая заболеваемость возвратным тифом регистрировалась в период военные действий, например, во время первой и второй мировых войн.
Распространению этого инфекционного заболевания способствует миграция населения, низкий уровень санитарной культуры, несоблюдение гигиенических навыков. Возможен завоз эпидемического вшивого тифа в благополучные страны беженцами или, например, кочующим цыганским табором.
Многим знакомы эти ситуации:
- Муж пропадает где-то с друзьями и приходит домой «на рогах»…
- Дома исчезают деньги, их не хватает даже от получки до получки…
- Когда-то любимый человек становится злым, агрессивным и начинает распускать руки…
- Дети не видят отца трезвым, только вечно недовольного пьяницу…
Если Вы узнали свою семью — не терпите это! Выход есть!
Анна Гордеева смогла вытащить мужа из ямы. Эта статья произвела настоящий фурор среди домохозяек!
Общая характеристика возбудителя
Спирохета Обермейера (она же Borrelia reccurentis, в дословном переводе – возвратная боррелия). Имеет клеточную оболочку, внутри нее содержится ДНК. В зависимости от фазы заболевания форма боррелий меняется: от продолговатой в острый период, до неправильной в промежуток клинического благополучия.
Спор и капсул боррелия не образует. Размножается делением. Хорошо окрашиваются традиционными в микробиологии анилиновыми красителями. Боррелии чувствительны практически ко всем воздействиям внешней среды. Они быстро гибнут под влиянием нагревания, действии УФО и дезинфектантов.
Особенностью боррелий является достаточно высокая антигенная изменчивость – под влиянием антибактериальной терапии формируются штаммы, которые уже устойчивы к действию этих антимикробных препаратов.
Эпидемиологические особенности
Источником инфекции в этом случае является только больной человек. Наиболее опасна с точки зрения количества возбудителя кровь.
Заразное начало этой биологической среды, возможность заражения именно через кровь было подтверждено еще в конце 19 века одесским морфологом Г.Н. Минхом в опыте по самозаражению кровью больного возвратным тифом.
Подобный опыты самозаражения были повторены впоследствии его коллегой О.О. Мочутковским и всемирно известным ученым И.И. Мечниковым.
Трансмиссивный путь передачи этой инфекции реализуется посредством укуса вши, преимущественно платяной, реже головной и лобковой.
Вошь кусает больного человека, получая возбудитель возвратного тифа, после этого она мигрирует на человека еще здорового, кусает его и заражает. Особенностью укуса любой вши является сильнейший кожный зуд.
Удержаться от расчесов практически невозможно – человек втирает в собственную кожу спирохету Обермейера.
Больной человек в нормальной гигиенической обстановке, то есть без вшей, для окружающих опасности не представляет.
Клиническая картина
Изменения в различных органах и тканях обусловлены, в первую очередь, воспалительно-дистрофическими процессами в сосудистом русле. Инкубационный период обычно ограничивается неделей, реже растягивается на 14-15 дней.
У человека, заболевшего эпидемическим возвратным тифом, наблюдаются:
- В большом количестве вши (любые);
- высокая лихорадка с ознобом, мышечной и головной болью;
- беспокойство и двигательное возбуждение;
- вздутие живота и его болезненность;
- увеличение размеров печени, а также селезенки;
- желтушное окрашивание кожи, иногда геморрагическая сыпь.
После 5-7 дней высокой температуры она резко снижается, состояние больного улучшается. Далее следует 5-14 дней нормальной температуры, после чего возникают предвестники и новый приступ. В зависимости от степени тяжести течения заболевания больной может перенести от 3 до 5 приступов лихорадки.
Заболевание может осложниться развитием массивного кровотечения, разрывом селезенки, вторичными бактериальными осложнениями. При этом летальность не превышает 1%.
Общие принципы диагностики и лечения
Специфическая диагностика эпидемического вшивого тифа основана на обнаружении спирохеты Обермейера в биологическом материале больного. Кровь пациента может быть подвергнута специфическому окрашиванию.
Важным моментов диагностики является биологический метод. Заражение морских свинок материалом, содержащим спирохету Обермейера, не приводит к развитию у них болезни. Это является одним из ключевых отличий эпидемического тифа от эндемического.
Лечение основано на применении антибиотиков (левомицетин и тетрациклиновая группа), инфузионной дезинтоксикационной терапии. Обязательно проводится дезинсекция одежды и других предметов, чтобы не допустить дальнейшего распространения инфекции.
Эндемический возвратный тиф
Так называемый клещевой возвратный тиф (его же называют эндемическим) – заболевание с природно-очаговым характером, передающееся клещами. Характеризуется развитием лихорадки и общей интоксикации, а также возможным поражением нервной системы.
Этиология и эпидемиология
Развитие это заболевания могут вызывать порядка 20 видов боррелий. Они во многом сходны с возбудителем эпидемического вшивого тифа, то есть с боррелией Обермейера.
Переносчиком этого инфекционного заболевания являются клещи (орнитодовые). Заболевание распространено только в определенных регионах: сухих и жарких (пустынных) местностях, но регистрируется на всех континентах.
Всплеск заболеваемости совпадает с активностью клещей (сентябрь-октябрь, май-июнь).
Заболевание чаще всего развивается у туристов, приезжающих на отдых в эндемичную зону. Местное население приобретает иммунитет в результате бытовой иммунизации.
Клиника и осложнения
Клинические проявления во многом сходны с таковыми при эпидемическом возвратном тифе.
Отличаю данное заболевание отсутствие периодичности приступов лихорадки и апирексии, а также изменения в периферической крови.
Информация об укусе клеща и пребывании в эндемичной зоне помогает поставить правильный диагноз. Окончательный ответ специалист сможет дать после выявления соответствующей боррелии в крови больного.
Осложнения эндемичного клещевого тифа – это невриты, острый психоз, разрыв селезенки. При использовании антибиотиков летальность не превышает 1%.
Эндемический и эпидемический возвратный тифы в настоящее время – это редкие заболевания благодаря использованию антибиотиков.
Источник: https://infectium.ru/transmissivnye-infektsii/vozvratnyi-tif.html
Причины появления возвратного тифа
Возвратный тиф относится к спирохетозам, основная их особенность – приступы сменяются периодами затишья. Заболевание вызывает два вида лихорадки:
- эндемическую (клещевую);
- эпидемическую (вшивую).
Дифференциальная диагностика
Среди признаков выделяют приступы:
- лихорадки;
- интоксикацию;
- высыпания (кожные);
- небольшую желтушность;
- гепатоспленомегалию.
Чтобы установить правильный диагноз, нужно провести исследования крови. При этом заболевании будут обнаружены спирохеты. Лечение обязательно проводится с применением антибиотиков.
Возвратный тиф наблюдается практически по всей планете, кроме австралийских селений, в разных странах случаются его вспышки. Особенно им подвержены страны с низким уровнем жизни, плохой организацией условий быта и проживания. По частоте этого инфекционного заболевания лидирует Африка, тут встречается самая тяжелая форма тифа.
Общая информация
Природа заболевания инфекционная:
- протекает оно полициклично;
- между приступами лихорадки случаются периоды затишья;
- вызывать заболевание могут сразу две инфекции – клещевая и вшивая.
Оба вида объединены похожими по строению возбудителями, проявлениями и механизмом передачи. К их развитию приводит заражение спирохетами Borrelia: они очень быстро размножаются, проникая в состав крови в колоссальных количествах.
Боррелии
Borrelia вызывают зоонозные (болезнь Лайма) и антропонозные (возвратный тиф) инфекционные заболевания. В этом роде насчитывается 20 разновидностей, но большая их часть для человека безопасна. В природе боррелии и их переносчики постоянно взаимодействуют.
Клещевой тиф и вшивый принято рассматривать, как отдельные заражения. У них отличается структура спирохет, реакция иммунитета и эпидемиология. Если вовремя не изолировать больных, происходит развитие эпидемии.
Причины
Развивается эпидемический возвратный тиф после заражения спирохетой Обермейера. У нее форма спирали в 4–8 витков, такая спирохета очень подвижна. Источник заражения – больной человек, он опасен при лихорадке. Вшивый возвратный тиф переносится тяжелее клещевого, он вызывает осложнения.
Переносчики – вши, в большинстве случаев – платяные. Спирохеты проникают в них при сосании крови, а в гемолимфе они быстро размножаются. Здоровый человек заражается, если раздавит насекомое с инфекцией. При этом спирохеты могут проникнуть внутрь организма через расчесы и ранки на коже.
Эпидемический возвратный тиф распространяется при несоблюдении гигиены, массовой завшивленности. Потенциально опасными считаются места, где всегда много людей:
- казармы;
- тюрьмы;
- ночлежки.
Временное расположение в местах общего скопления является благоприятным для заражения. Особенно когда смешиваются разные слои населения.
Общее скопления людей первый признак заболевания
Во времена войн нередко это заболевание приобретало характер эпидемии. В Судане, например, во времена сороковых годах возвратным тифом болел каждый десятый.
Клещевой или эндемический возвратный тиф вызывают спирохеты Borrelia, они обитают практически в любом уголке Земли. Они очень близки со спирохетами Обермейера по морфологии и свойствам.
Если инфицированный клещ укусит человека, развивается клещевой возвратный тиф, эпидемии для этого вида тифа не свойственны. Чаще всего от возвратного тифа страдают жители Африки, Европы, Латинской Америки, Азии.
Симптомы тифа возвратного
Инкубационный период занимает от 3 дней до трех недель, затем больного лихорадит. Подскакивает температура, человек испытывает временный жар, озноб. Лихорадку сопровождают:
- слабость;
- боль в мышцах ног;
- головная боль;
- бессонница.
В пик лихорадки появляются симптомы конъюнктивита, инъекция сосудов склер, покраснение лица, появляется сыпь, случаются кровотечения из носа. Один из явных признаков – язык обретает нехарактерную повышенную влажность, становится припухшим, покрывается плотным белесым налетом. Такой налет легко снять, но он быстро появляется вновь.
Печень, селезенка при этом увеличиваются, через 5 дней часто появляется желтушность. Это связано с тем, что разрушаются клетки этих органов, появляются места некроза.
У крови есть бактерицидные свойства. Бореллии, попадая в кровоток, начинают разрушаться, выделяются токсины. Это приводит к общей интоксикации, повреждаются структуры ЦНС, кровеносной системы. Начинается рвота, олигурия, понос (со слизью).
Первая лихорадка протекает 5–8 дней, при этом иммунитет начинает работать особенно активно. Потом 1–2 недели наблюдается апирексия (промежуток между лихорадками).
После лихорадки больной страдает от гипергидроза, у него наблюдается пониженное давление, при этом язык становится чище, возвращается аппетит, уходят проявления интоксикации.
Боррелии могут быстро менять антигенные свойства, потому вырабатывают устойчивость к иммунитету больного. Даже после появления антител в организме человека они продолжают свое активное размножение и разрушительное воздействие. Лишь когда организм достигнет максимальной выработки антител разного спектра, болезнь начнет отступать.
Особенные случаи
При апирексии человеку становится легче, но недомогание, слабость остаются. Затем начинается вторая волна лихорадки, симптомы ее те же. Второй приступ короче – 4 дня., интервал без лихорадки удлиняется, приступы повторяются о 3 до 5 раз. Следующий приступ короче, чем предыдущий, протекает легче.
У некоторых больных наблюдается лишь один приступ лихорадки. Это связано с правильным и своевременным лечением. Если же терапия отсутствует, болезнь будет быстро прогрессировать, лихорадочные приступы могут повторяться 10 и более раз.
При тифоидном наблюдается геморрагическая сыпь, желтуха, профузный понос, в интервалах пирексии температура остается повышенной. При септическом развиваются абсцессы внутренних органов, остеомиелит, пневмония, миокардит. Желчный тифоид часто приводит к летальности.
Прогноз для больных
Сейчас возвратный тиф быстро выявляют и успешно лечат. Осложнения и летальность наблюдаются у каждого сотого пациента. Очень опасно заразиться при беременности. Возвратный тиф вызывает кровотечения в матке, преждевременные роды.
Среди других осложнений встречаются:
- диффузный бронхит;
- пневмония;
- иридоциклит;
- неврит слухового нерва;
- гнойный отит.
После заражения стойкий иммунитет к заболеванию не вырабатывается.
Симптомы возвратного клещевого тифа
Начинается все с укуса маленького клеща, на месте повреждения остается мелкая папула с ободком. Инкубация занимает 5–15 дней, после нее начинается лихорадка.
Больной испытывает все проявления интоксикации. Длятся они 1–4 дня, перед началом апирексии температура резко падает. Приступов лихорадки часто бывает десять и больше.
Апирексия протекает от 2–3 дней до 3–4 недель, течение болезни – 2–3 месяца.
Клещевой возвратный тиф переносится легче. Его приступы короче, а апирексия длиннее. После выздоровления остается устойчивый иммунитет. Если больше укусов не будет (а это способ иммунизации), легко заболеть вновь.
Клещевая форма не летальна. Осложнения случаются реже.
Диагностика и лечение
Первая диагностика строится на показателях по эпидемической ситуации и проявившихся симптомах. Если установлено, что больной заразился, важно найти первичный аффект. Чтобы подтвердить диагноз, проводят диагностику в лаборатории, ее задача – обнаружить спирохет в крови. Иногда могут проводить биологическую пробу (морских свинок заражают инфицированной кровью больного).
Важно дифференцировать возвратный тиф от следующих нарушений:
- сыпного;
- бруцеллеза;
- малярии;
- гриппа.
При лечении обязательно используются антибактериальные средства (Ампициллин, Пенициллин, Тетрациклин, Эритромицин). Последнее время инфекционисты предпочитают использовать препараты нового поколения – Мафарсен, Мафарсид, Миарсенол, Новарсеноли, курс их приема – до недели.
При правильном лечении приступы лихорадки быстро купируются, дополнительно устраняются результаты интоксикации. Дезинтоксикация во время терапии важный этап, в крови таких больных содержится множество токсинов и спирохет.
Если наблюдается такое осложнение, как желчный тифоид, то в терапию включаются препараты сердечно-сосудистые.
Симптомами тупика во время лечения является не проходящая желтуха, частые и сильные кровотечения, нарушение ритма сердца.
В этом случае необходимо госпитализировать больного и изолировать его, для этого используется особый транспорт. Важно обеспечить обильное питье, постельный режим и адекватное комплексное лечение.
Профилактика
Меры специфической профилактики до сих пор не разработаны, прививки не существует. Чтобы предупредить его, важно выполнить следующие меры:
- постоянно бороться с педикулезом;
- следить за санитарно-гигиеническими условиями;
- своевременно выявлять заболевших и госпитализировать их;
- в очаге проводить активные мероприятия по дезинсекции и дезинфекции.
Важно истреблять возбудителей возвратного тифа, следует уничтожать клещей, грызунов. В очаге эпидемии важно защищаться от укусов зараженных клещей. Нужно использовать репелленты и специальную защитную одежду.
Возвратный тиф очень опасен, чтобы не заразиться, нужно создать достойные условия проживания, следить за чистотой, вовремя уничтожать грызунов.
Источник: http://ParazityTut.ru/bolezni/vozvratnyj-tif.html
Возвратный тиф
Возвратный тиф (рецидивирующая лихорадка) — вызывают некоторые виды бактерий рода боррелия. Распространение бактерий происходит через инфицированных клещей или вшей. Характеризуется повторяющимися эпизодами лихорадки, головной боли, мышечных и суставных болей и тошноты. Существует две формы рецидивирующей лихорадки:
- Эндемический возвратный тиф — клещевой возвратный тиф (эндемическая рецидивирующая лихорадка).
- Эпидемический возвратный тиф — вшивый возвратный тиф (эпидемическая рецидивирующая лихорадка).
Эпидемический возвратный тиф — вызван спиральными бактериями боррелия, которые передаются от человека человеку в результате прямого контакта с инфицированными тканями. Вспышки чаще всего встречаются в условиях высокой плотности населения и социального разлома (лагеря беженцев).
Эпидемии возвратного тифа часто возникали в Европе в начале 20-го века. Между 1919 и 1923 годами. Было зафиксировано 13 миллионов случаев, в результате которых 5 миллионов смертей. Эпидемический возвратный тиф обошел Россию и Восточную Европу стороной.
Сегодня эпидемический возвратный тиф вызывает спорадические заболевания и вспышки в странах Африки к югу от Сахары, особенно в регионах, пострадавших от войны и в лагерях беженцев. Широко распространён в Эфиопии, Судане, Эритрее и Сомали. Болезнь может быть тяжелой, смертность от 30 до 70% при вспышках эпидемии.
Приблизительно через 5 дней жар внезапно спадает, и человеку становится лучше. Однако лихорадка и обычно другие симптомы обычно возобновляются (рецидивируют) с 1–2-х недельными интервалами от 2 до 10 раз.
При лечении антибиотиками, с каждым эпизодом проявления носят все менее тяжелый характер, и, в конце концов, больной выздоравливает по мере выработки иммунитета к возбудителю заболевания.
Вшивый возвратный тиф — редкое явление, в основном инфекция имеет тенденцию к проявлению в масштабах эпидемии, особенно в регионах, где ведутся военные действия и организуются лагеря для беженцев. В этих местах зараженность вшами обычно хорошо заметна.
Пути передачи
Клещевой возвратный тиф встречается гораздо чаще и распространен по всему миру. Бактерии боррелия, которые вызывают эндемический возвратный тиф, передаются людям через укус зараженных «мягких клещей» рода Ornithodoros (семейство аграсовые, мягкотелые). Мягкие клещи отличаются двумя важными способностями от более привычных нам клещей.
- Во-первых, укус мягких клещей короткий, обычно длится менее получаса.
- Во-вторых, мягкие клещи не ищут добычи в высокой траве. Вместо этого они живут в норах грызунов, питаясь по мере необходимости на грызуне, когда он спит.
Люди обычно вступают в контакт с мягкими клещами, когда спят в каютах, зараженных грызунами. Клещи появляются ночью и кормятся ненадолго, пока человек спит. Укусы безболезненны, и большинство людей не знают, что их укусили. Между приемами пищи клещи возвращаются в свои норы к грызунам.
Существует несколько видов боррелия, которые вызывают клещевой возвратный тиф, и они обычно связаны с конкретными видами клещей. У каждого вида есть предпочтительная среда обитания и предпочтительный набор хозяев:
1.Ornithodoros hermsi имеют тенденцию обнаруживаться на более высоких расстояниях (от 450 до 2500 метров), где они связаны, прежде всего с наземными или деревенскими белками и бурундуками.
2.Ornithodoros parkeri встречается на более низких высотах, где они обитают в пещерах и норах сусликов и прерийных собак, а также в рощах.
3.Ornithodoros turicata встречается в пещерах и наземных белковых или прерийских собачьих норах в равнинных районах юго-запада, кормящих этих животных, а иногда других животных обитающих в норах или пещерах.
Мягкие клещи могут прожить до 10 лет; в некоторых частях России такой же клещ, как было установлено, прожил почти 20 лет. На каждом этапе жизненного цикла клеща его рацион может расширяться.
При этом некоторые виды могут передавать инфекцию своим потомкам.
Длительный срок жизни мягких клещей означает, что после того, как местность будет инфицирована, она может остаться зараженной до тех пор, пока не будут предприняты шаги для поиска и удаления гнезда грызунов, в котором обитают клещи.
Что можно сделать для предотвращения заражения возвратным тифом?
Отдыхающих на природе людей могут кусать инфицированные клещи, переносчиками которых обычно являются крысы. Однако поскольку клещи питаются по ночам и не остаются на коже надолго, люди зачастую не замечают укусов.
- Тщательно проверяйте местность, перед тем как разбить палаточный лагерь. Хотя гнезда грызунов не могут быть видны, другие свидетельства их активности (например, помет) являются признаком того, что местность может быть заражена.
- Предотвратите укусы клещей и контакты с грызунами — используйте репелленты.
Симптомы
Клещевой возвратный тиф характеризуется повторяющимися лихорадочными эпизодами, которые продолжаются 3 дня и разделены афебрильными периодами продолжительностью 7 дней. Наряду с лихорадкой, пациенты могут испытывать широкий спектр неспецифических симптомов.
Каждый лихорадочный эпизод заканчивается последовательностью симптомов, общеизвестных как «кризис». Во время «холодной фазы» кризиса у пациентов развивается очень высокая температура (до 41,5 C) и состояние становится бредовым, возбужденным, может развиться тахикардия.
Продолжительность от 10 до 30 минут. За этой фазой следует «флеш-фаза», характеризующаяся потерей пота и быстрым снижением температуры тела. Во время флеш-фазы пациенты могут стать временно гипотензивными.
Основные симптомы инфекции:
- Головная боль
- Миальгия
- Высыпание
- Озноб
- Тошнота, рвота
- Боль в животе
- Сухой кашель
- Глазная боль
- Затылочная жесткость
- диарея
- Боль в шее
На более поздних стадиях могут развиваться другие симптомы, к числу которых относятся: желтуха (пожелтение кожных покровов и конъюнктивы глаз), светобоязнь, артралгия, гепатомегалия (увеличение в размерах печени и селезенки), a также нарушение сердечного ритма или сердечная недостаточность. У беременных женщин возможен выкидыш.
Диагностика
Для диагностики возвратного тифа образец крови исследуют под микроскопом на наличие бактерий Боррелия.
Лечение
Обычно эффективными являются такие антибиотики, как тетрациклин, доксициклин или эритромицин.
В течение 2 часов после первой дозы антибиотика может возникнуть неприятная реакция (реакция Яриша-Герксгеймера), которая выражается в потении, ознобе, лихорадке и снижении артериального давления. Для снижения степени тяжести данной реакции до и после приема первой дозы антибиотика назначается ацетаминофен.
Способность бактерии боррелия уклоняться от действий иммунной системы
Рецидивирующая лихорадка вызвана некоторыми видами боррелия, грамотрицательными бактериями от 0,2 до 0,5 микрон в ширину и от 5 до 20 микрон в длину. Они видны с помощью световой микроскопии и имеют форму пробкового винта, типичную для всех спирохет.
Рецидивирующие спирохеты лихорадки имеют уникальный процесс перегруппировки ДНК, который позволяет им периодически менять молекулы на их внешней поверхности.
Этот процесс, называемый антигенной вариацией, позволяет спирохету уклоняться от иммунной системы хозяина и вызывать рецидивирующие эпизоды лихорадки и других симптомов.
Источник: https://infekt.ru/bakterialnye-infektsii/vozvratnyj-tif
Поделиться: